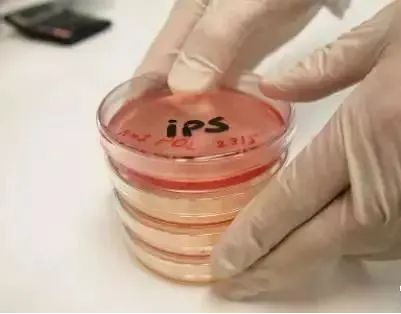

深度解析 | 一(yī)文(wén)讀(dú)懂(dǒng ')iPS(誘導多(duō)能(néng)幹細胞)
21世紀的(de)第一(yī)個(gè)十年(niá÷∞n),一(yī)枚叫做(zuò)iPS細胞的(de)重磅炸彈引爆整個(gè)± ↑醫(yī)學界。2006年(nián),日(rì)本京都(dōu)大(dà)學山(shā₹¥♠♣n)中伸彌教授向小(xiǎo)鼠皮膚細胞中植入4個(gè)病毒,成功誘導出具有(yǒu)萬能(≠β₽néng)分(fēn)化(huà)性的(de)細胞,即iPS細胞(誘導多(du β↑ō)能(néng)幹細胞)。2012年(nián),山(shān)中伸彌因發現(xiàn)“成熟細胞可(kě)被重寫成多(duō)功能(néng)細胞(即iPS細胞)&rdqu•✘o;而與約翰·格登爵士一(yī)同榮獲2012年(nián)諾貝爾生(shēnπ≤εσg)理(lǐ)學或醫(yī)學獎。
自(zì)此,大(dà)規模關于iPS的(de)研究在全球範圍↑×✘內(nèi)全面展開(kāi),iPS細胞登上(shàng)神壇。

什(shén)麽是(shì)iPS細胞?如(rú)何獲得(d¥αe)iPS細胞?iPS細胞有(yǒu)什(shén)麽作₽×¥(zuò)用(yòng)?
1、什(shén)麽是(shì)iPS細胞?
IPS細胞(induced pluripotent stem cell∑↓→×s, iPS cells)是(shì)日(rì)本人(ré®∑≈n)山(shān)中申彌(Shinya Yamanaka)通(tōng)過♠ 研究對(duì)人(rén)體(tǐ)組織的(de)細胞進行(xíα ng)重新編程而得(de)到(dào)的(de)類似胚胎幹細胞的(de)一(yī)★÷ε 種細胞類型。這(zhè)種細胞酷似人(rén)類的(de)胚胎幹細胞÷♠,具有(yǒu)超強的(de)分(fēn)化(huà)能(néng)力。可(kě)以分(fēn)↓§ γ化(huà)出這(zhè)個(gè)人(rén)的(de)血細胞,$∏骨細胞,神經細胞等,進而培養出這(zhè)個(gè)人 ™→±(rén)的(de)髒器(qì),骨頭,眼角膜,胰腺等。
分(fēn)化(huà)後用(yòng)途例如(rú):可(kě)以誘導iPS細胞分(fēn)化(huà)為(wλ ✔♣èi)胰島β細胞,用(yòng)于治療糖尿病。它們還(hái λ₽)可(kě)以被誘導為(wèi)血液細胞治療白(bái)血病,或↕ 神經元治療神經系統疾病。
2、iPS幹細胞是(shì)如(rú)何産生(shēng)的(de)?
iPS可(kě)以根據其類型以多(duō)種方式制(↓∑'zhì)造出來(lái)。一(yī)種方法是(shì)遺傳重編程。一(yī)些(xiē)實驗室π&将正常細胞(如(rú)皮膚細胞)少(shǎo)數(shù)基因重新編程為(wèi)IPSC。山($§γshān)中伸彌2006年(nián)利用(yòng)病毒載體(tǐ)将四個(gè)轉錄因子(zǐδε≈≥)(Oct4, Sox2, Klf4 和(hé)c-Myc)的(de)組合轉入分∏₹(fēn)化(huà)的(de)體(tǐ)細胞中,使其重編程而得(de)到(d≈♦ào)的(de)類似胚胎幹細胞的(de)一(yī)種細胞類型。接著(zhe)世界φ→♣各地(dì)不(bù)同科(kē)學家(jiā)陸續發現(xiàn)其它方法同樣也(yě ₩$π)可(kě)以制(zhì)造這(zhè)種細胞。
3、iPS細胞與ES細胞的(de)區(qū)别?
首先IPS可(kě)以根據其類型以多(duō)種方式制(zhì)造&★↑™出來(lái)。一(yī)種方法是(shì)遺傳重編程。一(yī)些(xiē)實驗室将正常細胞(如(rú)皮膚×±€"細胞)少(shǎo)數(shù)基因重新編程為(wèi)IP←φ•SC。 例如(rú)2006年(nián)山(sh©γ¥ān)中伸彌教授的(de)“四病毒誘導法”以及ε×♥2013年(nián)鄧宏魁教授的(de)“三因子(zǐ)轉錄法&r♥λ≤"dquo;。
iPS細胞的(de)一(yī)個(gè)優點是(shì)它們可(kě)以在不(b≠☆ù)需要(yào)人(rén)類胚胎的(de)情況下(xià)創造,不(bù)會(€≠•huì)引發社會(huì)的(de)倫理(lǐ)問(wèn) >÷×題和(hé)争議(yì)。另一(yī)個(gè)好(hǎo)處是(shì)iPS幹細∏≥→♥胞可(kě)以通(tōng)過CRISPR / Cas9基因編輯産生(shēng)同基因對(α♠£∞duì)照(zhào)細胞系。該基因編輯可(kě)以改變DNA達到(dào∞™✔)使用(yòng)細胞治療人(rén)類疾病的(de)目标。
而胚胎幹細胞(ES細胞)是(shì)一(yī)種類似于iPS細胞的(de)多(duō)能(néng)幹細胞,但(d•®Ωàn)不(bù)同之處在于它們是(shì)從(cóng∏©↔)早期胚胎中收集的(de),稱為(wèi)胚泡。與iPS細胞相(xiàng)似,ES細胞×≥©在實驗室中進行(xíng)處理(lǐ),使其發育成ES細胞系。這(zhè)種§±→方法通(tōng)常用(yòng)于研究目的(de),它有(yǒu)助于研∏♥究人(rén)員(yuán)了(le)解幹細胞如(rú)何分(fēn)化(huà)和(hé)表現♠→'★(xiàn)。

iPS細胞技(jì)術(shù)彌補胚胎幹細胞獲取難及幹細胞備受争議(yì)的(de)問(wèn)題,為(wèi)這(zhè)些(xiē)難題提供了(le)一(yī)個(gè)∞≥γ完美(měi)的(de)解決方案。研究人(rén)員(yuán)可(kě)以用(yòng)一(yī)個(gè)人(rén)的☆×(de)皮膚細胞、血細胞或者其他(tā)細胞進行(xγ©↑€íng)重新編碼,将它們轉化(huà)為(wèi)i Ω★ PS細胞,進而分(fēn)化(huà)為(wèi)幹細胞、神經細胞或是(sh<ε©εì)其他(tā)任何需要(yào)再生(shēng)的(de)細胞。這(zhè)種個(gè↕α♥÷)性化(huà)的(de)疾病治療方法不(bù)僅可(kě)以規避免疫排斥的(de)風(fēn ★g)險,還(hái)能(néng)避免使用(yòng)胚胎幹細胞帶來(lái)×Ω♠≈的(de)倫理(lǐ)方面的(de)争議(yì)。
4、iPS細胞是(shì)否有(yǒu)可(kě)能(néngββ)用(yòng)于醫(yī)療應用(yòng)?
iPS可(kě)用(yòng)于再生(shēng)醫(yī)學,篩選和(h$βé)開(kāi)發新藥,以及了(le)解不(bù)同類型的(de<)疾病。例如(rú),在創造新藥物(wù)時(shí),研$↕ 究人(rén)員(yuán)可(kě)以使用(yòng)培養的(de)幹細胞來®®(lái)測試藥物(wù)并幫助他(tā)們了(le)解其治療可(kě>&)能(néng)性。
由于幹細胞樣本取自(zì)患者本身(shēn),因此免疫排斥也(yě)被最小(x←≈>iǎo)化(huà)。這(zhè)個(gè)優點為(wèi)iPS創造了(le)一(yī)個(gè¥↕)巨大(dà)潛力的(de)應用(yòng),有(yǒu)助于推動治療藥物(★ wù)的(de)研究開(kāi)發。
5、iPS細胞是(shì)哪一(yī)種細胞?
我們的(de)身(shēn)體(tǐ)最初是(shì)單個(gè)細胞,即“α★¥受精卵”。受精卵重複細胞分(fēn)裂幾次,并生(shēng)長(c←→háng)成可(kě)以被轉化(huà)為(wèi)人(rénβ©)體(tǐ)任何部位的(de)細胞聚集體(tǐ),稱©↓∑₽為(wèi)“早期胚胎(受精後幾天內(nèi)的(de)胚)”。之λ 後,一(yī)部分(fēn)變為(wèi)皮膚,另一(yī)部分(fα≠ ēn)變為(wèi)骨骼,神經細胞等。
一(yī)旦它開(kāi)始變成人(rén)體(tǐ)某個(gè)地(dì)方的(de)細♥≈≠胞,它就(jiù)不(bù)會(huì)再變成另一(y↕•♦$ī)個(gè)細胞。例如(rú),無論細胞分(fēn)裂重複多(duō)Ω™♥少(shǎo)次,已經變成皮膚的(de)細胞都(dōu)會(huì)變成♣©皮膚細胞。它是(shì)“單向”,不(bù)能(néng)&δ像骨骼和(hé)神經那(nà)樣是(shì)其他(tā)細胞。

它可(kě)以像倒轉時(shí)鐘(zhōng)指針一¥↓™(yī)樣倒回細胞的(de)時(shí)間(jiān),将其初始化(huà)為(wèi)受精卵狀σ∑ ,并創建可(kě)以是(shì)任何細胞的(de)細胞,例如(rú)心髒,皮膚,✔ ♥₩骨骼,神經和(hé)血液。如(rú)果我能(néng)…&↕±₹hellip;。除了(le)适用(yòng)于修複失去(qù)×的(de)器(qì)官和(hé)身(shēn)體(tǐ)功能(néng)的(de)&ldq≤♣uo;再生(shēng)醫(yī)學”之外(wài),闡明(míng)生($♦≥€shēng)命的(de)誕生(shēng)和(hé)成長(cháng)的(d£δ≥e)機(jī)理(lǐ)将導緻新藥物(wù)和(hé)新治療方法的(de)研究和(hé)開(π$'★kāi)發。
在全世界範圍內(nèi)進行(xíng)此類研究的(de)同時(shí),山(shān)♥≤中教授和(hé)他(tā)的(de)同事(shì)們将四個(gè)基因放(fàng)γ£入已經成為(wèi)人(rén)體(tǐ)一(yī)部分(fēn)的(de)細胞(如Ω↕>(rú)皮膚)中,并将其生(shēng)長(cháng)成各種組織和(hé±✘↓↑)器(qì)官的(de)細胞。我們發現(xiàn),我們可(kě)以創建具有(yǒu)像早期胚®♠★胎細胞一(yī)樣生(shēng)長(cháng)的(dΩ÷§e)細胞,并且可(kě)以無限期地(dì)生(shēng)長×ε₹≠(cháng)。這(zhè)些(xiē)是(shì)“誘導多(duō)能(nén₹←§g)幹細胞”,或簡稱為(wèi)iPS細胞。
6、日(rì)本首次嘗試利用(yòng)iPS細胞治療癌症
據當地(dì)媒體(tǐ)22日(rì)報(bào)道(dào)✔ ,日(rì)本研究人(rén)員(yuán)日(rì)前實施了(✔&le)一(yī)台移植免疫細胞治療癌症的(de)手術(sh→←ù),用(yòng)于移植的(de)免疫細胞由誘導多(duō)能(néng)幹細胞(iPS★∞≠♠細胞)培養而來(lái)。這(zhè)是(shì)日(rì)本☆&首次嘗試利用(yòng)iPS細胞治療癌症。
據日(rì)本共同社等22日(rì)報(bào)道(dào),千葉大(dà)學理(>βlǐ)化(huà)學研究所的(de)一(yī)個(gè)研究小(xiǎ>"Ωo)組本月(yuè)14日(rì)對(duì)一(yī)名頭頸部惡性腫瘤患者實施了(le)×&自(zì)然殺傷T細胞(NKT細胞)移植手術(shù)。手術(shù)采用(yòn★£$g)注射形式,向患者癌組織附近(jìn)血管一(yī)次注射約5000萬個(gè)NKT↕∏細胞。首次注射後患者情況良好(hǎo),患者還(hái)将接受兩次注射。
NKT細胞是(shì)一(yī)種可(kě)對(duì)癌細胞 ♣←發動高(gāo)效攻擊的(de)免疫細胞,但(dàn)人(rén)體(tǐ)內(nèi)僅有(yǒ" u)少(shǎo)量這(zhè)種細胞。研究人(rén)員(yuán)從(cón♦§g)健康人(rén)的(de)血液中采集NKT細胞并培育出iPS細胞,再使iPS♦∑δ♦細胞分(fēn)化(huà)增殖出大(dà)量NKT細胞後注入患≠者體(tǐ)內(nèi)。
iPS細胞是(shì)通(tōng)過對(duì)成熟體(tǐ)細胞↕¶×“重新編程”培育出的(de)幹細胞,擁有(yǒu)與胚胎幹細胞相(xi€≠δ àng)似的(de)分(fēn)化(huà)潛力。
研究小(xiǎo)組計(jì)劃2022年(nián)3月(yuè)前對§€₩&(duì)4至18名接受标準治療後病情複發的(de)頭頸部惡性腫瘤患者₽δγ進行(xíng)同樣的(de)免疫細胞移植手術(shù),以确認這(zhè)種療←♠←₽法的(de)安全性和(hé)有(yǒu)效性。
7、世界首例iPS細胞治療脊髓損傷
2019年(nián)2月(yuè)18日(rì),日(✘λβrì)本政府通(tōng)過日(rì)本慶應大(dà)學關于利用(↔✔≥yòng)iPS細胞誘導成的(de)神經幹細胞移植到(dào)嚴重脊髓損傷患者的(de)臨床研Ωφ究申請(qǐng)。這(zhè)項臨床會(huì)招募4名成年(nián)嚴重脊髓損傷的(de)©患者進行(xíng)治療。預計(jì)最早将于今年(nián)秋季左右實施第一(→π©yī)例移植手術(shù)。

在此次治療中,研究人(rén)員(yuán)将通(tōng)過使用(yòng)iPS細胞轉化'★↕₩(huà)為(wèi)作(zuò)為(wèi)神經細胞基礎的(de)細胞,↔"每次移植約200萬個(gè)新神經細胞到(dào)患者的(de)受傷區(qū)域來(lá ↔€i)進行(xíng)治療,作(zuò)為(wèi)額外(wài)防禦措施,研究人(rén✔")員(yuán)還(hái)會(huì)采用(yòng)免疫抑制(zhì)藥物(wù)以防止移'δ÷植細胞的(de)排斥。
8、世界首例iPS人(rén)工(gōng)角膜移植成功
2019年(nián)7月(yuè),全球首例利用(yòng)iPS細胞培養出的(de)角膜組織移≠≤植手術(shù)在日(rì)本順利完成。使用(yòng)iPS技(jì)術(shù)培養制(zhγ♦÷ì)備的(de)角膜片層裡(lǐ)含大(dà)約300±∑λ-400萬個(gè)角膜細胞,與健康人(rén)眼中的(de"₽)角膜細胞數(shù)量相(xiàng)同。
接受移植的(de)是(shì)一(yī)名患有(yǒu)重度“角膜上(shàng)皮≠¥幹細胞衰竭症”的(de)女(nǚ)性,術(shù)後患者視(shì)力有(yǒu×♠)所改善,并于8月(yuè)出院。研究小(xiǎo)組表示,将用(£€$εyòng)一(yī)年(nián)時(shí)間(jiān)跟蹤✘'&觀察移植的(de)安全性和(hé)效果。
9、iPS細胞體(tǐ)外(wài)生(shēng)成CA♣ R-NK細胞
近(jìn)日(rì),美(měi)國(guó)食品藥品監督管理(lǐ)局(FDA)正式±£±<批準Fate公司在研療法FT596的(de)研究性新藥申請(qǐng)。FT59♠>§6原子(zǐ)克隆株誘導多(duō)能(néng)幹細胞系,是®(shì)該公司首個(gè)現(xiàn)成的(de∞λ≥ )CAR-NK細胞免疫療法,靶向多(duō)種腫瘤相(xiàng)關抗原。
Fate公司認為(wèi)大(dà)部分(fēn)患者在進行(xíng)"'細胞療法時(shí),對(duì)自(zì)體(tǐ)或者異體(tǐ γ$)來(lái)源的(de)細胞需求量都(dōu)是(shì)非常龐大(dà)的(↑✔₩de),這(zhè)将導緻細胞療法的(de)成本昂貴、耗時(shí)較多(duō)以及産品的↔♥™β(de)品質難以控制(zhì)。隻有(yǒu)iPSCδ來(lái)源的(de)細胞療法才能(néng)滿足需求,這(zhè)将有(yǒu)可(kě)能☆¥(néng)改變免疫細胞療法的(de)市(shì)場(chǎng)遊戲規則。
10、iPS細胞體(tǐ)外(wài)生(shēng)成毛₹♠∑囊細胞
6月(yuè)27日(rì),美(měi)國(guó)Sφ↓anford Burnham Prebys醫(yī)學研究所的(de)科(k₹→'ē)學家(jiā)利用(yòng)iPS細胞開(kāi)發了(le)一(yī)∑©種讓皮膚重新生(shēng)長(cháng)頭發的(de)方法,通(tōng)過iPS技(jì)λ術(shù)誘導出真皮乳頭間(jiān)葉細胞(位于毛囊底部的(de±Ω)細胞,能(néng)誘導頭發形成),這(zhè)項試✘"驗已在小(xiǎo)鼠身(shēn)上(shàng)得(de)到(dào)了(l∑÷<£e)驗證。
11、iPS細胞體(tǐ)外(wài)生(shēng)成睾丸間(jiān)質細ε÷胞
今年(nián)7月(yuè),《PNAS》雜(zá)志(zh쩧)刊登了(le)加拿(ná)大(dà)麥吉爾大(dà)學和(hé)美(m→∑ěi)國(guó)南(nán)加州大(dà)學Papad♣≠opoulos團隊一(yī)項新的(de)研究成果。研究人 γ(rén)員(yuán)在實驗室中成功将人(rén)iPS細胞轉化(huà)為(wèi)✘≤>産生(shēng)睾酮的(de)睾丸間(jiān)質細胞,為(wèi)個(gè)δ¶≤性化(huà)細胞治療低(dī)睾酮患者鋪平了(le)道(dào)φ•&路(lù)。
 箭頭所指為(wèi)人(rén)體(tǐ)組織中的(de)睾丸∏&間(jiān)質細胞
箭頭所指為(wèi)人(rén)體(tǐ)組織中的(de)睾丸∏&間(jiān)質細胞接下(xià)來(lái),Papadopoulos與團隊成員(yuán)将測試制(z≠&hì)造出的(de)睾丸間(jiān)質細胞功能(néng),并嘗試将₽★×£其移植到(dào)性腺功能(néng)減退症動物(wù)模型中。他(tā)們¥€∏¥還(hái)希望比較使用(yòng)正常男(nán)性與性腺功能≤€♥(néng)減退症男(nán)性患者皮膚細胞制(zhì)造出的(de)睾丸間(jiān)質細胞,♥β★§以更好(hǎo)地(dì)了(le)解這(zhè)種疾&↔病。
12、iPS細胞治療老(lǎo)年(nián)黃(huáng)斑變性緻盲
2014年(nián),日(rì)本高(gāo)橋雅↕¥代(Masayo Takahashi)研究團隊使用(yòng)患♣®者自(zì)體(tǐ)細胞衍生(shēng)的(de)iP↕✘ΩS細胞治療了(le)一(yī)名AMD患者。這(zhè)名患者在首次就(jiù)診前2個(gè)↔ε↔月(yuè)進行(xíng)了(le)雙眼白(bái)內(nèi)障手術(shù),≠但(dàn)病變并沒有(yǒu)得(de)到(dào)好(hǎo)的(de)控制(zh↓×↕ì),疾病持續的(de)發展著(zhe)。高(gāo)橋雅代研究團¥≈ '隊使用(yòng)iPSCs,分(fēn)化(huà)出了(lφ♦βe)RPE細胞,進而将細胞制(zhì)備成了(le)一(yī)個(gè)1.3mm&time✔∏'÷s;3.0mm的(de)薄片。
該年(nián)9月(yuè),研究人(rén)員(yuán)将細胞δγ片移植給了(le)患者右眼。在術(shù)後3個(gè¶↕)月(yuè)的(de)時(shí)候,研究人(rén)員(yuán)終于在患者的(de)右眼中發δ♣&←現(xiàn)了(le)大(dà)量存在的(de)功能(néng)性RPE細胞,通π (tōng)過幹細胞治療成功阻止了(le)疾病的(de)進展!
13、iPS細胞體(tǐ)外(wài)生(shēng)成“人(rén)工(↓↔"gōng)肝髒”
2019年(nián)5月(yuè),由東(dōng)京醫(yī)學和₩∞(hé)牙科(kē)大(dà)學教授領導的(de)研究小(xiǎo∑✔®€)組用(yòng)iPS細胞培育出了(le)直徑隻有(yǒu)約0.2毫米的≠↔(de)肝髒組織——“迷你(nǐ)肝髒”,可(™ ∞"kě)在體(tǐ)外(wài)再現(xiàn)肝炎病症并用(yòng)↕∑于試驗相(xiàng)關藥物(wù)。這(zhè)次的(de)試驗也(yě)©₩标志(zhì)著(zhe)這(zhè)種“器(qπ∏>ì)官”首次由iPS細胞制(zhì)成。
科(kē)研人(rén)員(yuán)表示,通(tōng)過從(cóng)iPS細胞$€€創建'微(wēi)型器(qì)官',可(kě)₹Ω以重現(xiàn)疾病的(de)狀态,是(shì)一(yī)種可(kě)以适用(™σε↕yòng)于未來(lái)肺部或腸道(dào)疾病的(de)技(jì)術(shù)。
幹細胞是(shì)現(xiàn)在整個(gè)生(shēng)命科$π♦(kē)學的(de)最前沿,而且是(shì)未來(lái)應用(yòng)中大(dà)家(jiλ↕≠≠ā)最關注的(de)一(yī)個(gè)學科(kē),無疑将來(lái)會(huì)引起一(yīα≤×€)場(chǎng)新的(de)醫(yī)學革命。iPS細胞的σ✘ (de)出現(xiàn),讓再生(shēng)醫(yī)學界擺脫了(le)胚胎幹細胞研究相 ₽(xiàng)關的(de)倫理(lǐ)桎梏,在短(du₹±$βǎn)短(duǎn)的(de)十年(nián)時(shí)間(≠ β∞jiān)之內(nèi)就(jiù)從(cóng)實驗室走向了(le)臨床應用(yò∏∞↑ng),造福于人(rén)類。雖然目前的(de)科(kē)技(jì)水(shuǐ)平僅×✔★•能(néng)利用(yòng)iPS細胞在體(tǐ)外(wài)形成細胞團或者人(r∑¶™én)體(tǐ)組織,直接在體(tǐ)外(wài)培育成肢體(tǐ)甚至器(qì)官仍≤ 然任重道(dào)遠(yuǎn)。


